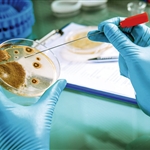

德国新研究发现:固态电池界面涂覆纳米涂层可让电池稳定
固态电池中的离子需要在多层材料界面中穿行,而这会带来一些挑战。据外媒报道,德国慕尼黑工业大学凯撒·威廉物理化学和电化学研究所和于利希研究中心的科学家们组成的一个团队表示,在此类材料界面上涂上纳米涂层,就可以让电池稳定。

电池内部(图片来源:慕尼黑工业大学)
固态电池被认为是下一代移动储能设备,有望增加电动汽车的续航里程,而且比现在所有电动汽车上搭载的、含有有机液体的传统电池更加安全。电池中的液体——电解质会有很多缺点:比固体电解质老化得更快,还容易燃烧。在汽车事故中,电池会暴露在机械应力下,可能会导致电池泄露,导致特别危险的事故。下一代电动汽车希望能够避免此类安全问题,同时还能够存储更多能量。因此,宝马、戴姆勒、福特和大众等大型汽车制造商都在大举投资研发高性能固态电池。
然而,截至目前,固态电池的商业化应用还不具有竞争力。虽然有了新的可能性,但也带来了新的挑战。在电池充放电过程中,离子(目前是锂离子)必须在电池内部的两极之间来回移动。固态电池中可移动的离子不再是在液体中移动,而是必须通过多个固相。因此,需要确保此类离子不会撞到材料和晶粒界面等高阻隔。这是因为离子传导介质——电解质不再由一个均匀的相组成,而是由许多连在一起的固体晶粒组成。为了让离子在连续不断的通道内扩散,在合成过程中,松散晶粒会被高压烧结,在此过程中,连接晶粒的界面上会形成薄膜,让离子很好地进行传输。
在固态电池的研究中,新形成的接触层的作用一直备受质疑。人们认为,固态电池界面上的变化只会产生不好的特性,因此总是试图将其影响降至最低。而凯撒·威廉物理化学和电化学研究所、慕尼黑工业大学和于利希研究中心的科学家小组刚刚发现,此类界面上的变化并不一定是不利的,事实上,可能会有积极的影响。
为了找到答案,该团队分析了电池内纳米大小的晶粒边界的功能。Rüdiger-A. Eichel教授表示:“这在以往的固态电池研究中,是从未涉及到的。直到现在,人们的重点还是集中在中观和宏观的研究上,但是根本无法足够了解该行为。”通过计算机模拟和实验研究,Christoph Scheurer博士团队成功在源自水平上描述了间相的特征。研究人员发现,此类间相实际上有助于实现电池的电化学稳定。
原因在于,形成的间相有助于抑制锂枝晶的成核。当电子和锂离子在电池内相遇时,此类触须状结构(枝晶)就会形成,然后会结合形成延伸的分支,很快会导致电池故障。一旦金属枝晶连接了电池的阳极和阴极,就会造成短路,电池就会出故障。慕尼黑工业大学博士生Sina Stegmaier表示:“在电池内部的晶粒之间自然形成极薄的一层,可作为保护涂层,抑制此种现象。”
此类研究成果在不久的将来会对固态电池研发产生重大影响。针对此类保护涂层形成间相可能是抑制枝晶形成的一条有发展前景的途径,可实现更持久、更安全的下一代电池。(盖世汽车)
相关文章
- 暂无资料
位及个人不得转载、摘编或以其它方式使用上述作品。已经本网授权使用作品的,应在授权范围
内使用,并注明“来源:中国涂界网”。违反上述声明者,本网将追究其相关法律责任。
2、凡本网注明 “来源:XXX(非中国涂界网)”的作品,均转载自其它媒体,转载目的在于传递更
多信息,并不代表本网赞同其观点和对其真实性负责。
3、如因作品内容、版权和其它问题需要同本网联系的,请在30日内进行。
※ 网站总机:0757-66840566 有关作品版权事宜请联系:0757-66840650 邮箱:tujiemedia@163.com